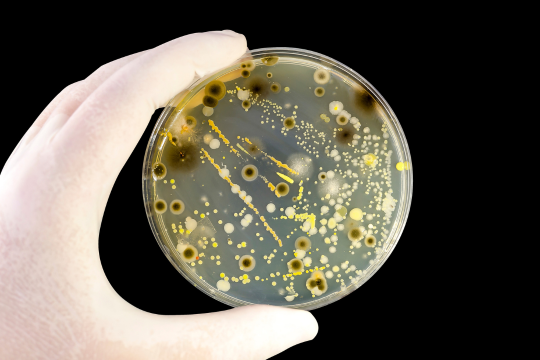

Mit über 950 Laboratorien in über 1.000 unabhängige Unternehmen in 59 Länder gibt es unzählige Beispiele dafür, wie unsere Arbeit und das herausragende Engagement unserer Wissenschaftlerinnen und Wissenschaftler seit 1987 entscheidend dazu beigetragen haben, die Grenzen des "Testing for Life" zu verschieben. Nachfolgend finden Sie eine Auswahl unserer Innovationen.

Busting the identical twin myth
Milestone research proves genetic differences
Salmon under threat – Detecting a new contaminant of concern
Developing the first test for 6PPD-quinone


Protecting transplant patients and saving lives
Immunity at the heart of the matter
New generation of non-invasive prenatal testing methods
Breakthrough genetic disorder determination


SNIF-NMR® - How it all began
Authenticity and origin testing to protect our food and drink
Helping to stop Zika in its tracks
Rapid real-time Zika test results


The future of bees, the future of life
Breakthrough science supporting better bee health
A pioneer in dioxins detection
Detecting one part out of 1,000 billion is not the limit


Acrylamide on the tip of everyone’s tongue
First to detect acrylamide in food
Testing for traceability of meat from farm to fork down to individual animals
Clarity and confidence for the food chain


The forefathers of pesticide testing
First multi-pesticide method in Europe
35 years of data for life
Building rich databases before Big Data


Finding adulteration even when not looking for it
Leading the way with non-targeted screening
Modern farming is precision farming
Farming and herd improvement testing – in six seconds


Beating drug-assisted rape forensically
Identifying knock-out drugs in hair
Out of the box product testing
When nothing is available, build your own robot


High-flying innovation
Unconventional inspiration for DNA synthesis
Testing for tailored cancer treatment
Empowering cancer research through innovation


A passive revolution in water sampling
From spot-checking to continuous environmental monitoring
Inventing the most sensitive heavy metals detection method
Testing for safety in soil, water, food and pharmaceuticals


Nurturing cells to grow
Culture media monitoring with Spedia NMR™
Solving old crimes with new technology
Eurofins’ new DNA software heats up cold cases


Leading the world in GM fish detection
Fast, reliable testing for genetically modified fish
Fuelling the first astronauts
Fortifying food for space

Not wanted! Dead or alive! Mould and bacteria
Eurofins’ new molecular methods enhance mould analysis
Safeguarding the health of the world’s most vulnerable consumers – Infants
Setting the new standard in infant formula testing


Tackling the big problem of tiny particles
Making microplastic testing commercially available
Protecting crops and human health at the same time
Developing the first test kit to detect glyphosate


20 million tests a month to help protect the world against COVID-19
Innovation and action during a global pandemic
Protecting cancer patients
Identifying high-risk patients following stem cell transplant


What do pizza boxes, raincoats and frying pans have in common?
Detecting PFAS in everyday products and our environment
Detecting a silent threat – transplant rejection
Optimising outcomes for kidney transplant patients


Seeking out a silent killer
Developing the first test to identify Radon
Fighting an animal health endemic
Limiting the spread of African Swine Fever


Ensuring liquid gold is the real deal
Innovative methods for fraud detection in honey
Algae, algae, everywhere. Toxic and what a stink
First rapid test for cyanobacteria toxins in water bodies


A new era of oncological data
Transforming cancer care through liquid biopsy
Changing the game in microbiological testing
High-throughput testing for higher quality data


An apple a day keeps the doctor away?
Detecting patulin contamination in fruit products
How safe is our drinking water?
Detecting an emerging disinfection by-product in drinking water

Read Science that makes an impact to learn more.
